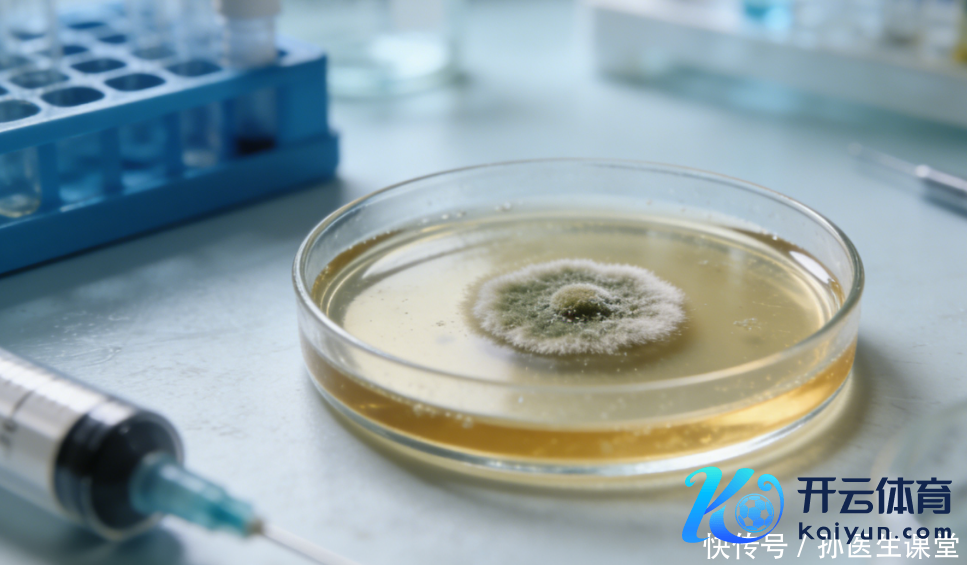

好多东说念主对“脑膜炎”的印象停留在“很严重、离我很远”。可在门诊里,真的让东说念主逗留的时时不是“听没听过这个病”,而是“症状像不像伤风、偏头痛、肠胃炎”。因为早期的不无礼,确乎可能和常见小过失长得很像:发热、头痛、乏力、恶心……这些词单拎出来,都不有数。
但身段的请示时时不在某一个单点,而在“组合”和“变化趋势”。脑膜炎并不是每个东说念主都会遭逢的事,也不是一出现头痛就该往最坏处想。更妥当的作念法是:学会识别更有提暗示旨的三类变化,必要时尽快让大夫评估,把该放置的风险放置去。

先用一个中国东说念主更好懂的比方。把大脑想成一锅细火慢熬的汤:温度、压力、环境都得厚实,滋味才正常。颅骨像锅盖,脑膜像锅盖内侧的一层“保温垫”和“防烫层”,既保护、又休止,还负责看护里面的“知道和顺序”。当这层“保护膜”发生炎症,就像锅里蓦的火大了、蒸汽多了,锅盖内壁还被烫得明锐——你会嗅觉到头里发胀、发紧、发疼,连光辉和声息都变得逆耳,脖子也不肯意动。
脑膜炎的原因并不只一,常见的有病毒、细菌等感染成分,也有少数与其他情况相关。不同原因的严重经过离别很大,是以科普不应把东说念主吓住,而是帮你把抓重心:哪些信号更值得深爱,什么本领“再不雅察”不合算,应该把判回绝给专科查验。

底下这3个变化,是相对更有提暗示旨、也更值得实时就医评估的“组合信号”。我会尽量少用术语,用更直白的说法评释它们为什么会出现,以及你在家里不错若何不雅察。
第一类变化:头痛的“本性”变了,不息、加剧,并且和发热纠缠在一皆。
不少东说念主的头痛是有律例的:熬夜后、病笃时、用眼过度后,像“欠账”相通来一下,休息、补水、消弱之后会缓解;或者偏头痛有我方的“套路”,比如某侧跳痛、陪伴恶心,对光明锐,但正常发热并不是主角。

更需要警惕的,是这一次头痛彰着“跟往日不相通”。它更像“锅盖里闷出来的胀痛”:不息握住、越来越重,以致一动就更疾苦,比如咳嗽、使劲、弯腰、高下楼时痛感加深。有的东说念主会描摹为“整个这个词头都不无礼”,不像单点钉子扎那样明确。更环节的是,它通常和发热一皆出现,且相互加成:烧着的本领头更痛,退烧后也并不竣工褪色,仅仅稍稍缓一缓,过一会儿又上来。
这里要阐述晰一个容易误解的点:发热+头痛并不等同于脑膜炎。流感、其他病毒感染也会这么。但若是你发现三件事重复出现——头痛不息、强度在飞腾、与发热相互纠缠,并且和你以往的头痛形态互异很大——就不提议靠“扛一扛、睡一觉”来赌运说念。至少应该就医评估,明确是不是需要进一步查验。

第二类变化:脖子“像生锈的门轴”,折腰远程、动掸良友,同期更怕光、怕吵,恶心想吐也更彰着。
好多东说念主第一响应会说“我落枕了”“颈椎不好”。落枕更像某一条肌肉拉伤,疼点明晰,转向某个角度会痛,但一般不太会和发热、彰着头痛同期“打包出现”。脑膜受到刺激时,身段常会出现一种更合座的“颈部发紧”:不是某块肌肉酸,而是脖子合座僵、折腰不无礼,以致下意志不肯意动。
你不错把它贯通为身段的“保护性刹车”。当头颅里面环境变得明锐,身段会本能地欺压行径幅度,就像车子出现异响时你会不自愿踩轻油门相通。这种“欺压动作”的嗅觉,若是和发热、不息头痛同期出现,就比单纯颈肩酸痛更值得深爱。

另外两种常见的陪伴变化也很环节:
一种是畏光、怕吵。你会合计灯光精通、手机屏幕晃眼,声息一大就烦,像“耳朵和眼睛被放大器放大了”。
另一种是恶心想吐。有些东说念主会误以为是胃病或吃坏了,但它更像“头里不无礼带来的砥柱中流”,以致出现喷射样吐逆,吐完也不磨蹭。

诚然,不是整个脑膜炎都一定出现这些典型组合,也不是出现了就势必是脑膜炎。但在“发热+头痛”的基础上,若是再重复“颈部彰着僵硬/折腰远程 + 畏光怕吵或彰着吐逆”,就提议尽快就医,让大夫通过查体和必要查验来判断下一步,而不是我方在家里反复对照。
第三类变化:整个这个词东说念主“情景分袂劲”,清爽度、响应、步履出现彰着偏差。
好多普通感染会让东说念主乏力,但一般还能正常疏导、正常判断。更让大夫驰念的是:一个东说念主蓦的变得特殊嗜睡、若何叫都良友;或者急躁、欣喜得不成比例,讲话前后不连贯;再或者响应彰着变慢,走路发飘,细心力很难纠合,像“脑子卡顿”。这种变化就像电脑的运行速率蓦的变慢以致死机,请示不仅仅“发热疾苦”那么浅陋。

不同庚齿段的推崇会不相通。
小孩子可能不会准确描摹头痛,只会用哭闹抒发不适:不息哭闹、若何哄都分袂,精神忽高忽低,吃奶彰着减少,变得格外黏东说念主或相背很“没劲”。
老年东说念主偶然也不以头痛为主,反而先推崇为精神情景调动、食欲骤降、整个这个词东说念主“跟平时不相通”。
若是你是照护者,比起盯着体温数字,更值得盯的是“东说念主有莫得变”:目光是否澄清,复兴是否对题,走路是否清静,就寝是否特殊。
这类“情景特殊”的信号,一朝出现,正常不提议络续在家不雅望。原因很浅陋:它不是靠你多喝水、多睡觉就能判断明晰的,需要专科评估来放置更需要实时处理的情况。
说完三类变化,你可能会问:那我到底该若何作念,才算“感性而不惊悸”?不错用一个浅陋的想路:看组合、看进展、看缓解情况。
看组合:单个症状不有数,组合更特别旨。比如仅仅发热,可能是普通感染;仅仅头痛,也可能是病笃或就寝不及;但发热与不息加剧的头痛重复,再出现颈部僵硬、畏光、彰着吐逆或精神情景特殊,提暗示旨就彰着加多。
看进展:普通伤风常是“今天疾苦、来日更像伤风、后天冉冉好转”。更需要警惕的是“越来越分袂劲”:头痛更重、吐逆更时常、精神更差、脖子越来越僵。这种“往坏标的走”的趋势,比某一次体温高更值得深爱。

看缓解情况:退热后精神能弗成回到接近平时?休息背面痛能弗成彰着缓解?补液、清淡饮食后恶心有莫得改善?若是你发现“若何作念都仅仅一刹好少许,很快又卷土重来”,也不提议络续硬扛。
好多东说念主驰念去病院会不会“查验太多”。从风险科罚角度看,实时就医评估的价值不仅是“确诊”,更迫切的是“放置”。大夫正常会把柄症状组合、查体情况决定是否需要进一步查验。你能作念的,是把踪迹证明晰,让判断更高效:

什么本领启动发热,最高些许度;头痛从什么本领启动,是胀痛还是跳痛,是不是越来越重;有莫得颈部僵、折腰远程;有莫得畏光怕吵;吐逆是不是时常,吐后是否缓解;精神情景是否特殊;近期是否有呼吸说念感染、泻肚,是否有与感染者密切斗争等。踪迹越明晰,大夫越容易作念出妥当有筹办。
在家里恭候就医或路上,有几条“更妥当的作念法”也值得说清。第一,尽量别自行重复多种药物,尤其不要纵欲使用抗生素。抗生素不是“退烧全能钥匙”,用错不仅有害,还可颖异扰后续判断。第二,细心补水与休息,但不要用“能喝水就没事”来判断轻重。第三,若是出现彰着意志不清、反复吐逆止不住、抽动样推崇或精神情景蓦的恶化等情况,应尽快寻求急诊评估,不要在家里反复不雅察到天亮。

缓慢层面,其实莫得奥妙招数,更多是把“感染传播的门”关紧少许,把“身段挣扎力的电量”肆虐少许。律例作息、减少永恒熬夜和过度倦怠,是在给免疫系统充电;勤洗手、咳嗽打喷嚏细心庇荫、室内透风,是在减少传播契机;孩子按法子完成相关疫苗接种,是把一部分可缓慢的风险挡在门外;在东说念主员密集、透风差的环境里,出现发热咳嗽等症状时减少近距离斗争,亦然对我方和他东说念主的保护。
还想相当提醒少许:聚积上常把某些症状说得相当“圭臬”,大致对上两条就能自测。真实情况是,东说念主体互异很大,推崇不一定教科书式整皆。你要收拢的不是“我有莫得竣工相宜”,而是“我此次是不是彰着不同、是不是在加剧、是不是出现了颈部僵硬和情景特殊这类更值得警惕的信号”。当你拿不准时,最合算的战略时时不是络续猜,而是让专科查验把不细目性尽快降下来。

临了把要点再收束一下,便捷你记着:
第一,头痛不息、加剧,且与发热纠缠在一皆,形态彰着异于以往。
第二,颈部彰着僵硬、折腰远程,同期怕光怕吵、恶心吐逆更高出。
第三,整个这个词东说念主情景特殊,嗜睡、响应变慢、言行分袂劲,尤其儿童和老年东说念主更要看“东说念主有莫得变”。

出现这些变化,并未便是一定是脑膜炎,但它请示你“该作念一次稳健评估”。科普不是让你发怵,而是让你在环节时刻更会分绘身绘色:该不雅察的不雅察,但别把彰着的特殊看成普通小过失拖着。
本文仅用于健康科普与风险请示开云官网切尔西赞助商,弗成替代面诊判断。若症状加剧、出现彰着特殊情景或你拿不准轻重,请实时就医评估。